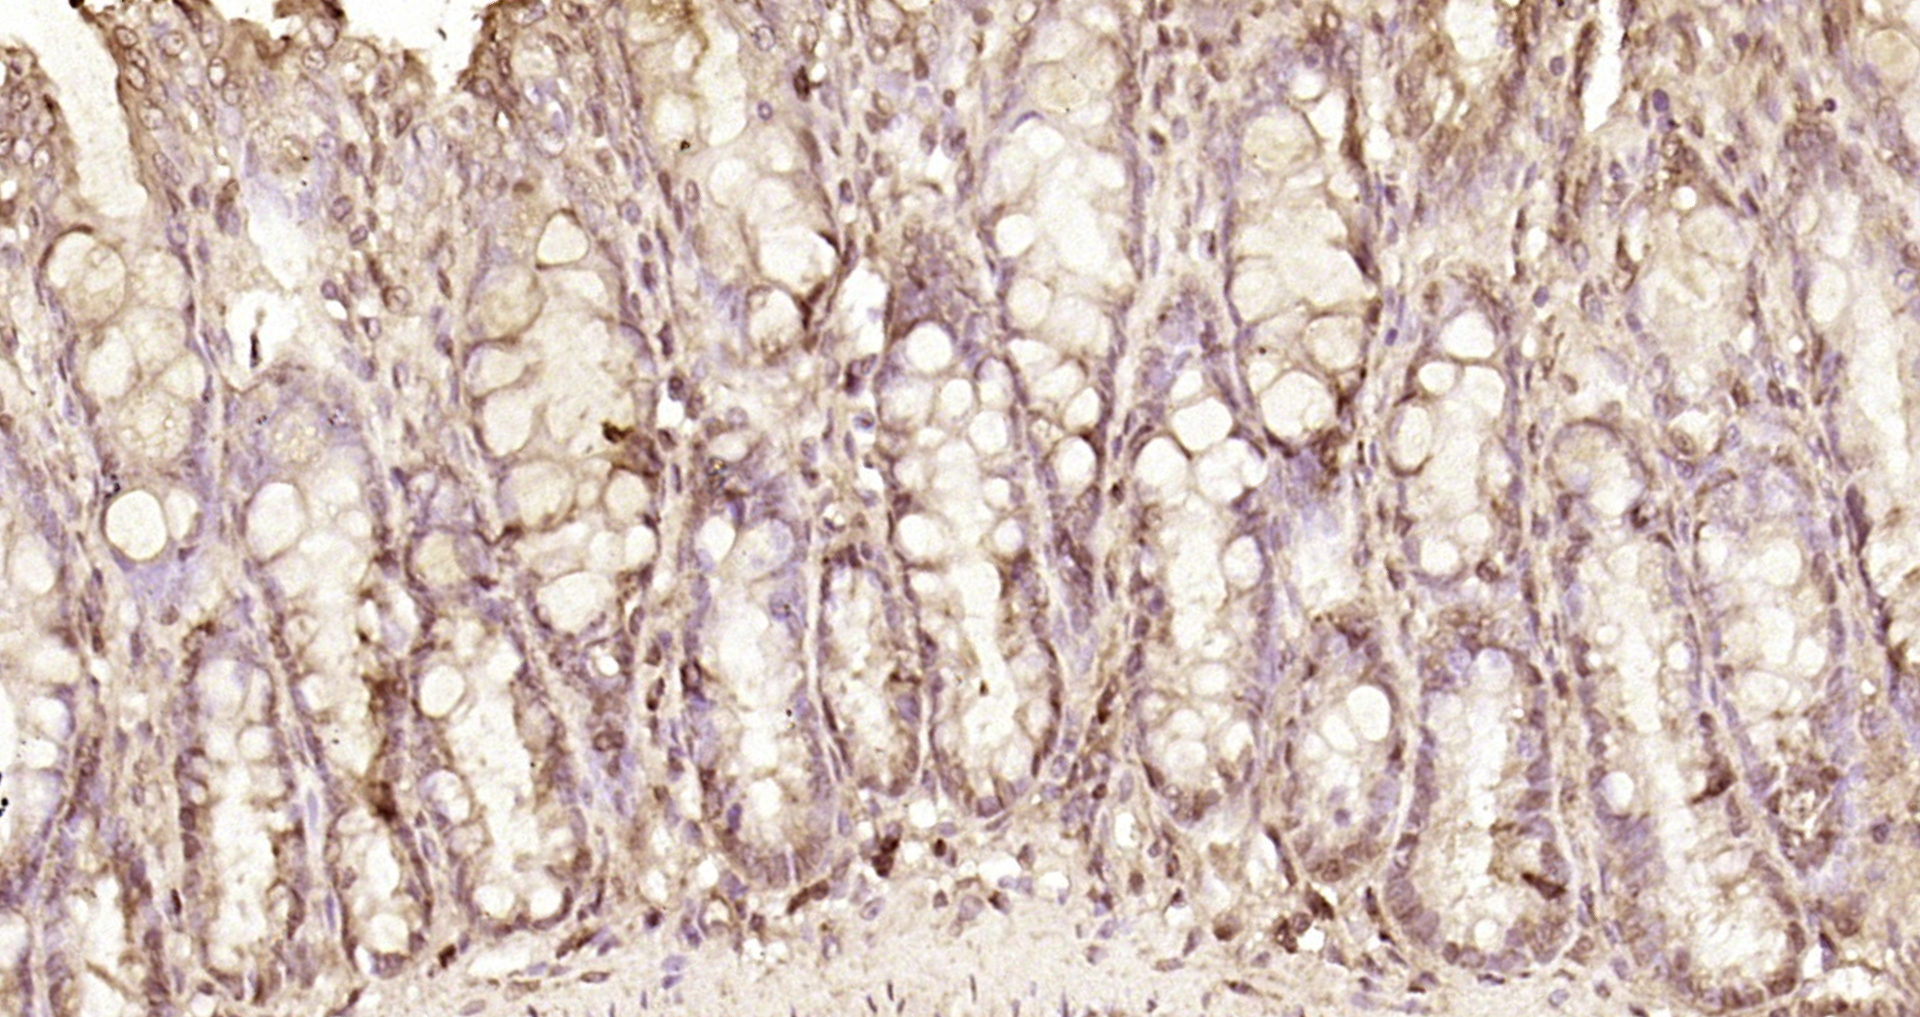
Paraformaldehyde-fixed, paraffin embedded Rat colon; Antigen retrieval by boiling in sodium citrate buffer (pH6.0) for 15min; Block endogenous peroxidase by 3% hydrogen peroxide for 20 minutes; Blocking buffer (normal goat serum) at 37°C for 30min; Antibody incubation with NOL8 Polyclonal Antibody, Unconjugated (bs-6554R) at 1:200 overnight at 4°C, DAB staining.

Rabbit anti-NOP132 Antibody, Affinity Purified
A302-722A
ApplicationsImmunoPrecipitation, Western Blot, ImmunoHistoChemistry
Product group Antibodies
ReactivityHuman
TargetNOL8
Product A302-722A is not available
Product not available
There may be an alternative product available, please contact our technical support team.
Overview
- SupplierBethyl Laboratories
- Product NameRabbit anti-NOP132 Antibody, Affinity Purified
- Delivery Days Customer9
- ApplicationsImmunoPrecipitation, Western Blot, ImmunoHistoChemistry
- CertificationResearch Use Only
- ClonalityPolyclonal
- Concentration1000 ug/ml
- ConjugateUnconjugated
- Estimated Purity...
- Gene ID55035
- Target nameNOL8
- Target descriptionnucleolar protein 8
- Target synonymsC9orf34, NOP132, bA62C3.3, bA62C3.4, nucleolar protein 8, nucleolar protein Nop132
- HostRabbit
- IsotypeIgG
- Protein IDQ76FK4
- Protein NameNucleolar protein 8
- ReactivityHuman
- Storage Instruction2°C to 8°C
- UNSPSC12352203